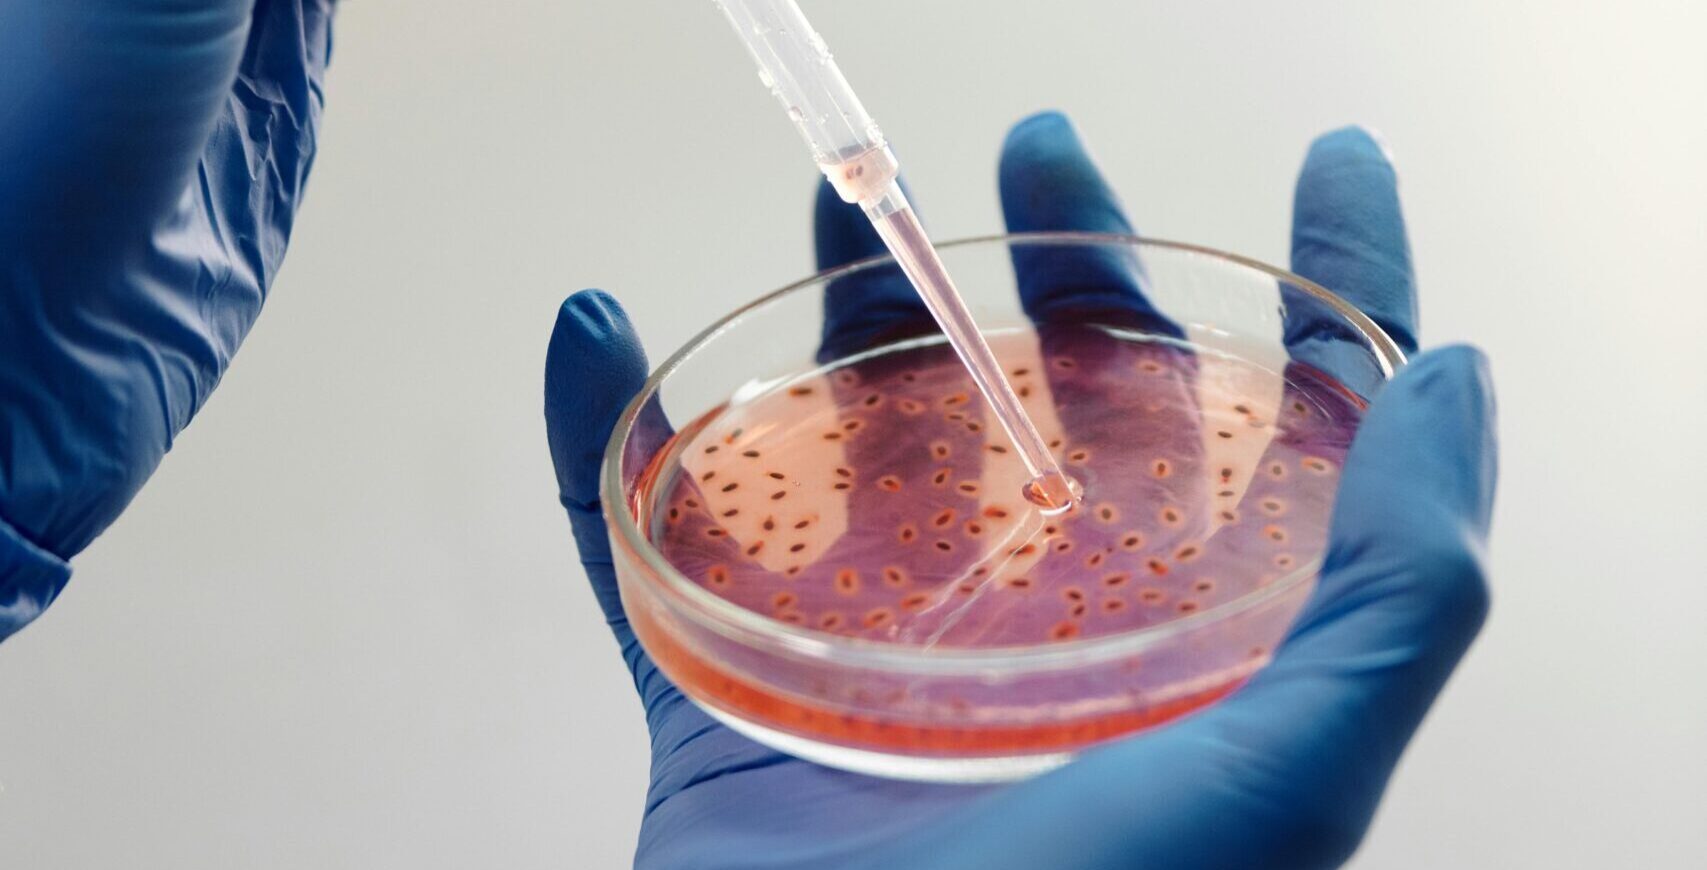

Współczesna gastronomia to nie tylko smaczne potrawy i estetyczna prezentacja, ale przede wszystkim bezpieczeństwo konsumentów. Klienci oczekują nie tylko kulinarnych doznań, ale także pewności, że spożywane przez nich produkty są wolne od zagrożeń mikrobiologicznych i chemicznych. Dlatego badania wody i żywności w gastronomii stanowią jeden z fundamentów funkcjonowania lokali gastronomicznych.
Właściciele restauracji i firm cateringowych odgrywają kluczową rolę w zapewnianiu jakości serwowanych potraw. To na nich spoczywa odpowiedzialność za spełnienie wymagań sanepidu dla gastronomii, wdrażanie odpowiednich procedur oraz nadzór nad higieną i kontrolą surowców.
Każdy lokal gastronomiczny podlega rygorystycznym przepisom sanitarnym, które regulują sposób przygotowywania, przechowywania i serwowania żywności. Przepisy sanitarne dla lokali gastronomicznych określają m.in. obowiązek regularnego monitoringu jakości wody oraz żywności wykorzystywanej do przygotowywania posiłków.
Zgodnie z rozporządzeniami UE oraz przepisami krajowymi, przedsiębiorcy muszą wdrażać procedury zapewniające bezpieczeństwo żywności w restauracjach, co obejmuje również cykliczne badania mikrobiologiczne wody i żywności.
Wymagania sanepidu dla gastronomii dotyczą nie tylko czystości pomieszczeń czy higieny personelu, ale również systematycznego kontrolowania jakości surowców. Brak aktualnych wyników badań, uchybienia w dokumentacji lub nieprawidłowości w procedurach mogą skutkować nałożeniem kar finansowych, a w skrajnych przypadkach – zamknięciem lokalu.
Dlatego obowiązki właścicieli restauracji nie kończą się na zakupie dobrego sprzętu czy zatrudnieniu kucharzy – muszą oni także zapewnić zgodność ze wszystkimi wymogami sanitarnymi, w tym prowadzenie rzetelnych analiz i dokumentacji.
Badania wody w gastronomii obejmują zarówno analizę mikrobiologiczną (np. obecność bakterii Escherichia coli, enterokoków kałowych), jak i fizykochemiczną (np. pH, przewodność, zawartość azotanów). Celem tych badań jest wykrycie ewentualnych zagrożeń i niedopuszczenie do ich przedostania się do żywności.
Dobrej jakości woda ma kluczowe znaczenie nie tylko przy gotowaniu, ale także w procesach mycia warzyw, naczyń czy rąk personelu. Zaniedbania w tym zakresie mogą prowadzić do poważnych zagrożeń zdrowotnych.
Badania wody w gastronomii powinny być wykonywane regularnie – najczęściej raz w roku lub częściej, jeśli sanepid tego wymaga. Próbki należy pobierać zgodnie z określonymi procedurami, najlepiej przez personel laboratorium lub przeszkolonego pracownika lokalu.
Właściwa dokumentacja próbki – miejsce pobrania, data, temperatura, sposób transportu – ma ogromne znaczenie przy ocenie wiarygodności wyników.
W przypadku stwierdzenia nieprawidłowości, np. przekroczeń norm mikrobiologicznych, właściciel lokalu zobowiązany jest do podjęcia natychmiastowych działań naprawczych – np. dezynfekcji instalacji wodnej, zmiany źródła wody lub ponownych badań. Taka kontrola jakości wody i żywności to nie tylko wymóg prawny, ale też praktyka, która bezpośrednio przekłada się na jakość usług.
Badania żywności w restauracjach to kluczowy element systemu zapewnienia bezpieczeństwa żywności. Obejmują m.in. analizę mikrobiologiczną (np. Salmonella, Listeria, gronkowce koagulazo-dodatnie) oraz chemiczną (np. poziom azotanów, pestycydów, metali ciężkich).
Pobieranie próbek powinno odbywać się w sposób planowy i udokumentowany. Współpraca z akredytowanym laboratorium zapewnia wiarygodność wyników. Dobrze opracowany plan badań uwzględnia różne grupy produktów – mięso, warzywa, produkty mleczne czy dania gotowe.
Wyniki analiz służą nie tylko jako dowód spełnienia wymagań sanepidu dla gastronomii, ale przede wszystkim – jako narzędzie poprawy jakości wewnętrznych procesów. Regularne badania żywności w restauracjach pozwalają wykryć źródła zanieczyszczeń i szybko wdrożyć działania korygujące.
System HACCP w gastronomii (Hazard Analysis and Critical Control Points) to zintegrowane podejście do zarządzania bezpieczeństwem żywności, oparte na analizie ryzyka i kontroli punktów krytycznych. Wdrożenie HACCP jest obowiązkowe dla wszystkich zakładów gastronomicznych.
Badania mikrobiologiczne wody i żywności są nieodłącznym elementem systemu HACCP. Wyniki analiz służą jako podstawa do walidacji i weryfikacji procedur, a także stanowią element dokumentacji wymaganej podczas kontroli sanepidu.
Właściciele, którzy skutecznie wdrożyli HACCP, zyskują nie tylko spokój w kontekście spełnienia przepisów, ale również realne narzędzie do zarządzania jakością. Normy higieniczne w gastronomii są wówczas monitorowane w sposób systemowy, co ogranicza ryzyko błędów i poprawia reputację lokalu.
Wybór zaufanego partnera do badań to kluczowy krok. Laboratorium powinno posiadać akredytację PCA oraz doświadczenie w analizach dla sektora HoReCa. Współpraca powinna obejmować nie tylko wykonywanie analiz, ale też doradztwo w zakresie interpretacji wyników.
Stały harmonogram badań wody i żywności ułatwia zarządzanie ryzykiem i zapewnia ciągłość danych. Dokumentacja powinna być uporządkowana i dostępna na wypadek kontroli. Obowiązki właścicieli restauracji obejmują nie tylko samo wykonanie badań, ale także ich archiwizację i analizę.
Nawet najlepiej opracowany system nie zadziała bez przeszkolonego zespołu. Dlatego tak istotne jest regularne szkolenie personelu z zakresu norm higienicznych w gastronomii, zasad dobrej praktyki higienicznej (GHP) oraz reagowania na sytuacje awaryjne.
Badania wody i żywności w gastronomii to nie dodatek, lecz konieczność. Stanowią fundament bezpieczeństwa żywności w restauracjach i są obowiązkiem wynikającym z prawa. Regularna kontrola wody i żywności, wdrożenie systemu HACCP w gastronomii, a także przestrzeganie przepisów sanitarnych dla lokali gastronomicznych nie tylko chronią zdrowie konsumentów, ale również budują zaufanie do marki oraz minimalizują ryzyko kar ze strony organów kontrolnych.
Dla właścicieli restauracji i firm cateringowych oznacza to konieczność ciągłego monitorowania, dokumentowania i doskonalenia procedur wewnętrznych. Pamiętajmy, że obowiązki właścicieli restauracji nie kończą się na spełnieniu minimum wymaganego przez wymagania sanepidu dla gastronomii. Coraz więcej klientów oczekuje nie tylko smaku, ale też pełnej transparentności i gwarancji jakości.
Dlatego inwestycja w regularne badania mikrobiologiczne wody i żywności, współpraca z rzetelnymi laboratoriami, szkolenie personelu oraz wdrożenie realnie działającego HACCP to działania, które powinny być wpisane w strategię każdego profesjonalnego lokalu gastronomicznego.
Chcesz otrzymywać informacje o naszych aktualnych działaniach? Zapisz się do newslettera i bądź na bieżą
Badania mikrobiologiczne, chemiczne oraz badania i pomiary środowiska pracy
Sprawdź listę badańWzorcowanie alkomatów, mierników, termometrów i innych przyrządów pomiarowych
Sprawdź listę wzorcowań